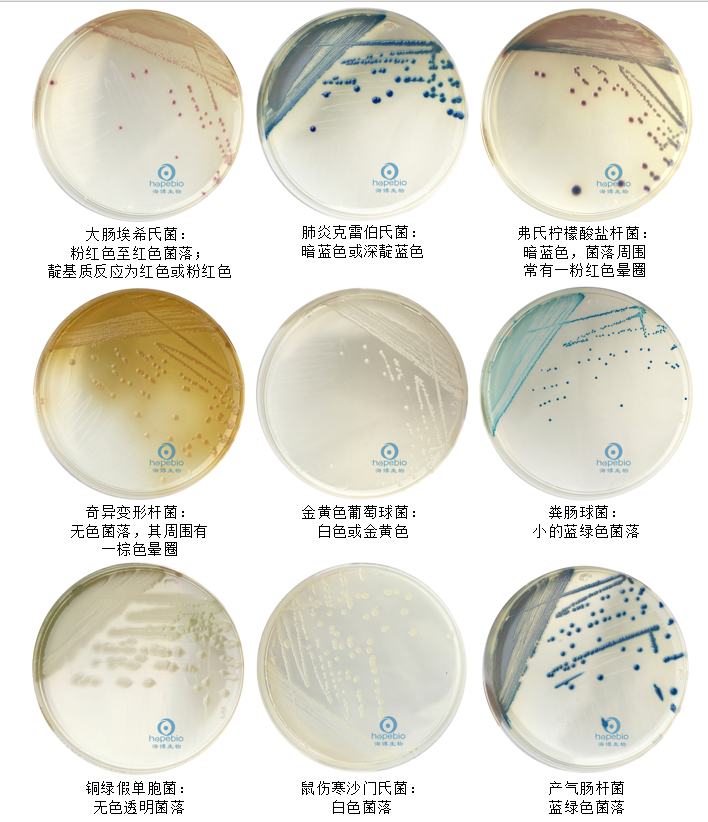

海博微信公众号
海博微信公众号
 海博天猫旗舰店
海博天猫旗舰店


 海博微信公众号
海博微信公众号
 海博天猫旗舰店
海博天猫旗舰店




说明
微生物耐药性的日益严峻和医院感染控制的迫切需求,对病原体检测技术的时效性和准确性提出了更高要求。显色培养基作为一类新型诊断工具,通过微生物特异性代谢酶与底物发生反应释放显色基团,使不同种属的微生物呈现特征性颜色,从而实现快速分离和初步鉴定。本文将系统探讨显色培养基在临床病原体检测中的最新应用进展及其对诊疗模式的变革性影响。
一、显色培养基在真菌感染诊断中的核心作用
念珠菌属是临床最常见的侵袭性真菌病原体,占深部真菌感染的87.5%-94.5%。传统沙保罗培养基(SDA)虽可支持念珠菌生长,但存在两大缺陷:一是无法区分不同念珠菌种类,二是易受肠杆菌科细菌污染(假阳性率达21.5%)。念珠菌显色培养基通过整合特异性酶底物以及选择性抑制,完美解决了这些难题。
如青岛海博生物的念珠菌显色培养基(货号HB7015):白色念珠菌生成绿色菌落;热带念珠菌生成蓝灰色菌落;光滑念珠菌生成淡紫色-紫色菌落;克柔念珠菌(即图中的克柔氏假丝酵母菌)生成紫粉色菌落;酵母菌生成灰粉色菌落;其他念珠菌生成白色菌落;细菌(如大肠埃希氏菌)被抑制而不生长,如图1所示。该显色培养基对不同念珠菌种类进行了区分,并且其选择性抑制能力使肠杆菌科污染率降至接近于零,可见其显著优于传统方法。

图1 不同菌在念珠菌显色培养基上的菌落特征
二、尿路感染病原菌快速诊断中的突破
尿路感染(UTI)作为第二大常见感染性疾病,病原谱复杂且混合感染率达15%。传统血平板和麦康凯培养基需结合生化试验,流程长达3天-5天。然而尿道定位显色培养基不仅可以极大缩短诊断时间(36℃±1℃培养18 h-24 h小时),而且可以揭示混合感染。
参考青岛海博生物的尿道定位显色培养基(货号HB7013),该培养基是青岛海博生物公司改良的培养基,用于导致尿路感染主要微生物的初步鉴定和分离培养;是一种无抑制性显色培养基;经培养,大肠埃希氏菌显粉红色至红色;肠球菌为小菌落,显蓝绿色;肺炎克雷伯氏菌显暗蓝色或深靛蓝色;弗氏柠檬酸盐杆菌显暗蓝色,菌落周围常有一粉红色晕圈;变形杆菌为无色,菌落周围有一棕色晕圈;金黄色葡萄球菌为白色或金黄色菌落;铜绿假单胞菌为无色透明菌落;鼠伤寒沙门氏菌为白色菌落;产气肠杆菌为蓝绿色菌落(如图2所示)。
尿道定位显色培养基通过多色反应系统实现了革兰氏阴性杆菌和革兰氏阳性球菌的同步鉴别,更关键的是其可以揭示混合感染:当大肠埃希氏菌与粪肠球菌共存时,传统血平板因前者过度生长而掩盖后者,而显色培养基通过颜色差异可清晰识别两者,避免漏诊导致的用药失误。
图2 不同菌在尿道定位显色培养基上的菌落特征
三、耐药菌筛查:院感防控的关键工具
1、ESBLs肠杆菌的快速锁定
超广谱β-内酰胺酶(Extended Spectrum Beta-Lactamases,ESBLs)是以灭活窄谱和广谱头孢菌素、单环类抗生素及抗-革兰阴性杆菌青霉素等抗生素为特征的β-内酰胺酶。大肠杆菌、肺炎克雷伯杆菌、鲍曼不动杆菌等通常最易生产,其次,阴沟肠杆菌、粘质沙雷氏菌、弗劳地枸橼酸菌、绿脓杆菌也可生产。其特点是可以水解灭活青霉素类抗生素、头孢菌素(主要为第三代头孢菌素,如头孢他啶、头孢哌酮等,马斯平等除外)和单环β-内酰胺类抗生素(氨曲南、卡芦莫南等),通常不水解头孢霉素类(头孢西丁、头孢美唑等)和碳青霉烯类(亚胺培南、美罗培南等)。其活性可以被克拉维酸、舒巴坦、他唑巴坦等β-内酰胺酶抑制剂所抑制。临床常用纸片扩散法、稀释法(包括筛选和确证两种试验)进行检测。
产超广谱β-内酰胺酶(ESBLs)肠杆菌对多种抗生素耐药,易引起医院内暴发流行。参考生物梅里埃(bioMérieux)公司的ChromID ESBLs,该新型ESBLs显色培养基通过添加头孢噻肟(ESBLs酶解底物)和显色底物(如5-溴-4-氯-3-吲哚苷),使耐药菌呈现特征性颜色:产ESBLs大肠埃希菌生成紫红色菌落;产ESBLs肺炎克雷伯菌生成蓝绿色菌落。
在110例粪便标本筛选中,该培养基检出ESBLs阳性菌的灵敏度达97.7%,与金标准方法(酶抑制剂增强试验)符合率95.3%。值得注意的是,显色培养基将检测时间从传统方法的72小时缩短至24小时,为接触隔离和抗菌药物调整赢得关键窗口期
孕妇生殖道B族链球菌(GBS)携带是新生儿败血症的主要感染源。参考法国科玛嘉B族链球菌显色培养基(CHROMagar-GBS),该培养基通过添加色素底物X-GAL(5-溴-4-氯-3-吲哚-β-D-半乳糖吡喃糖苷),使GBS水解后呈现橙色/红色菌落。在519份阴道分泌物检测中,其与传统培养法的符合率达99.61%,阳性率11.18%,显著优于免疫学方法,成为围产期感染防控的一线工具。
四、结语
显色培养基通过将生化反应可视化,在病原体鉴定领域实现了速度与精度的双重突破。其在念珠菌分型、尿路感染快速诊断及耐药菌筛查中的卓越表现,不仅优化了临床决策路径,更推动了微生物检验向“精准化”和“可及化”发展。随着技术创新与临床需求的深度耦合,显色培养基将从单一的鉴定工具演变为集耐药性评估、毒力预测和感染控制于一体的整合型诊断平台,为精准抗感染治疗提供核心支撑。“微生物世界的色彩密码正在被破译——显色培养基让病原体无处遁形,将实验室的复杂解码过程转化为肉眼可见的直观答案”。(本公司有显色培养基类产品,详情请见表1)
表1 青岛海博生物显色培养基类产品信息
|
产品编号 |
产品名称 |
规格 |
产品说明及用途 |
|
HB7015 |
1000mL |
用于念珠菌分离和鉴定,白色念珠菌显绿色 |
|
|
HB7013 |
1000mL |
用于导致尿路感染的主要微生物 的初步鉴定和分离培养 |
|
|
HB7003-7 |
1000mL |
用于快速、准确同时检测大肠杆菌和大肠菌群, 培养24小时, 大肠杆菌显蓝色-紫色,大肠菌群显红色 |
|
|
HB7006 |
1000mL |
用于O157菌的显色培养, O157菌显亮红色、淡红色或红色 |
|
|
HB7008 |
1000mL |
用于李斯特氏菌的显色培养, 单增李斯特氏菌显蓝色, 外围有一不透明环 |
|
|
HB7009-5 |
1000mL |
用于金黄色葡萄球菌的显色培养, 金黄色葡萄球菌显紫红色 |
|
|
HB7010-1 |
1000mL |
用于霉菌和酵母菌的显色培养 |
|
|
HB7011-5 |
1000mL |
用于弧菌的显色培养,副溶血性弧菌显蓝绿色, 霍乱弧菌和创伤弧菌显紫红色, 溶藻弧菌显淡黄色或米黄色 |
|
|
HB7012-1 |
200g |
用于阪崎肠杆菌的显色培养, 阪崎肠杆菌显蓝色,其它肠杆菌显无色 |
|
|
HB7007-1 |
1000mL |
用于沙门氏菌的显色培养, 沙门氏菌显紫色 |
|
|
HB7014-1 |
1000mL |
用于肠球菌的显色培养, 肠球菌显红色至紫红色 |
注:本文属海博生物原创,未经允许不得转载。
上一篇:舌尖上的微生物:发酵食品有哪些?
下一篇:没有了!
| 相关文章: | ||



